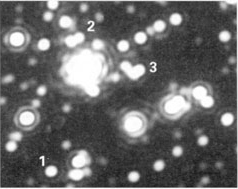

Konfokální mikroskop
V uplynulých dvaceti letech zaznamenala optická mikroskopie pozoruhodný rozmach, a to jak v důsledku vysoké kvality nových objektivů navrhovaných počítači, tak díky spojení mikroskopů s vyspělou videotechnikou a následným zpracováním obrazů výkonnými mikropočítači či laserovými zdroji světla. Technický pokrok pozměnil optickou mikroskopii do té míry, že je dokonce patrná jistá renezance jejího užití v buněčné biologii, kde v poválečném období jednoznačně dominovala mikroskopie elektronová. Jednou z novinek je konfokální mikroskopie – metoda zajímavá nejen skvělými experimentálními možnostmi, které nabízí badatelům v mnoha oborech, nýbrž i samotným principem zobrazování.
Optický mikroskop
Obyčejný optický mikroskop se skládá z objektivu, který vytváří zvětšený, převrácený obraz zkoumaného předmětu, a okuláru, jímž tento obraz pozorujeme jako lupou (obrázek). Další důležitou částí mikroskopu je zdroj světla s kondenzorem. Zkoumané předměty lze vidět jen díky tomu, že zobrazující záření s nimi nějakým způsobem interaguje. Světlo může být pozorovaným objektem částečně absorbováno, jindy se spíš lomí, odráží nebo rozptyluje, při průchodu objektem se mění fáze světelného vlnění, někdy i jeho polarizace. Některé objekty také mohou emitovat fluorescenci. Nakolik se libovolný z uvedených jevů bude podílet na vzniku obrazu, závisí v první řadě na optických vlastnostech objektu.
Skutečnou roli určitého optického jevu, a tím i vzhled obrazu, však nakonec určuje zejména volba mikroskopické techniky. K nejpoužívanějším patří:
- pozorování ve světlém poli (základní metoda, s níž se určitě setkal každý, kdo s mikroskopem někdy pracoval ve škole),
- pozorování v temném poli,
- fázový kontrast,
- diferenciální interferenční kontrast,
- Hoffmannův modulační kontrast,
- interferenční mikroskopie,
- polarizační mikroskopie a fluorescenční mikroskopie.
Pro srovnání s konfokálním mikroskopem není podstatné, jaká je povaha technických rozdílů mezi jednotlivými metodami. Důležité je naopak to, co mají všechny společné: zobrazují celý objekt najednou, veškeré jeho body zároveň.
Rozlišovací schopnost mikroskopu
Pod rozlišovací schopností mikroskopu se chápe minimální vzdálenost dvou bodů objektu, které se ještě zobrazí jako navzájem oddělené. Žádný objektiv nemůže zobrazit bodový objekt opět jako bod. I při dokonalé korekci všech možných vad zobrazení, které souvisí s technologií výroby objektivů, jsou obrazem bodu Airyho kroužky (obrázek). Tak se nazývá difrakční obrazec vznikající ohybem zobrazujícího se světla na čočkách objektivu. Při zobrazení dvou blízkých bodů se mohou jejich Airyho kroužky překrývat, až se při jisté minimální vzdálenosti stanou téměř nerozlišitelnými. Tato mez se běžně odhaduje dle Rayleighova kritéria (1879), které v podstatě vychází ze skutečnosti, že lidský zrak zaznamená pozvolný předěl mezi dvěma difrakčními kroužky teprve tehdy, poklesne-li intenzita mezi nimi alespoň o 20 % oproti přilehlým maximům. Pro modré světlo (viditelné záření nejkratších vlnových délek) se teoretická rozlišovací schopnost blíží hodnotě kolem 0,17 m. Praktická rozlišovací schopnost reálných objektivů závisí ovšem také na tom, jak dokonale se při výrobě podaří zkorigovat různé vady zobrazení.Pozorování trojrozměrných objektů
Skutečné mikroskopické objekty jsou trojrozměrné, čímž se míní, že mají konečnou tloušťku. Teoretické rozlišovací schopnosti mikroskopu lze plně využít jen v případě vzorků o tloušťce menší, než je hloubka ostrosti objektivu, která závisí na jeho numerické apertuře (Zmin = 0,25 nλ/NA2). Při zkoumání silných vzorků, například tkáňových řezů nebo velkých buněk, je kvalita zobrazení, a tím i praktická rozlišovací schopnost mikroskopu, nepříznivě ovlivňována překrýváním obrazu roviny, do níž je mikroskop právě zaostřen, s neostrými obrazy rovin ležících nad ní a pod ní. Rušivého zamlžení obrazu zářením z mimoohniskových rovin se lze do značné míry zbavit pomocí konfokální mikroskopie.Idea konfokálního mikroskopu pochází od Marvina Minského, který si ji patentoval již r. 1957. V té době však zůstala bez odezvy, neboť Minsky nenašel vhodný zdroj světla pro konstrukci funkčního přístroje. O deset let později M. Petráň a M. Hadravský z Lékařské fakulty UK v Plzni patentovali konfokální mikroskop na bázi rotujícího Nipkowova kotouče. S tímto přístrojem (v odborné literatuře je znám pod názvem Tandem Scanning Confocal Microscope) byly poprvé získány kvalitní optické řezy silným preparátem, konkrétně mozkovou tkání. Tandemový konfokální mikroskop však nedoznal většího rozšíření v praxi. Éra konfokální mikroskopie začíná až koncem sedmdesátých let, kdy byl zkonstruován první spolehlivý konfokální mikroskop s rozmítaným laserovým paprskem. Nikoli náhodou to bylo ve stejné době, kdy se staly běžně dostupnými výkonné minipočítače. Nyní je na trhu zhruba 10 verzí konfokálního mikroskopu.
(Laser Scanning Confocal Microscope)
Konfokální obrazy a rozlišovací schopnost konfokálního mikroskopu. Při rastrování je měřená intenzita světla registrována počítačem spolu s informací o souřadnicích analyzovaného bodu. Díky prostorové filtraci záření dopadajícího na detektor neobsahuje obraz vytvořený počítačem neostré pozadí pocházející z mimofokálních oblastí vzorku. V tomto smyslu jsou konfokální obrazy vždy zaostřené a představují optické řezy vzorkem. S objektivem o numerické apertuře ~ 1,3 a při použití modrozelené čáry argonového laseru (λ = 488 nm) činí tloušťka optických řezů asi 0,4 m. Prostým vertikálním posouváním vzorku vůči objektivu je navíc umožněno pozorovat optické řezy v různých hloubkách pod povrchem. Rozdíl mezi obyčejnou a konfokální fluorescenční mikroskopií demonstruje obr. pod článkem.
Potlačení mlhavého pozadí obrazu a optická tomografie (zobrazování rovinných řezů vzorkem) nejsou jediným přínosem konfokálního zobrazování. Teoretická rozlišovací schopnost konfokálního mikroskopu se totiž nezakládá na Rayleighově kritériu, jelikož konfokální obraz objektu vzniká postupným skládáním z jednotlivých bodů, které jsou navíc pozorovány přes clonku, jejíž rozměry bývají menší než průměr Airyho kroužků. Je-li průměr konfokální clonky roven nejvýše 1/4 průměru centrálního maxima Airyho kroužku, je rozlišovací schopnost konfokálního mikroskopu přibližně o faktor 1,4 lepší než rozlišovací schopnost standardního mikroskopu o stejné numerické apertuře objektivu.
Potíže plynoucí z metody sériového snímání obrazových bodů. Každé
měření intenzity světla je zatíženo statistickým šumem, jehož velikost je úměrná √N/N, kde N je počet detegovaných fotonů. Je proto zřejmé, že čím slabší je detegované světelné záření, tím horší bude relativní přesnost stanovení intenzity v sousedních bodech, tj. obrazový šum. Zdánlivě přímočarý způsob zvyšování intenzity detegovaného signálu zvýšením výkonu laserového zdroje je málokdy přípustný. Zejména při fluorescenční konfokální mikroskopii bývá maximální intenzita budicího záření omezena nežádoucím zvyšováním rychlosti fotochemických reakcí fluoreskujících molekul, po nichž mizí fluorescence (anglicky “photobleaching″). Jestliže intenzitu budicího laserového záření nemůžeme libovolně zvyšovat, musíme zvýšit dobu akumulace signálu, pokud chceme dosáhnout přijatelné úrovně šumu. Běžná doba snímání jednoho optického řezu s rozlišením 512 × 512 bodů o 256 úrovních jasu se pohybuje od 0,5 do desítek sekund. To ovšem znamená, že při konfokální fluorescenční mikroskopii slabě zářících objektů nelze z principiálních důvodů dosáhnout zároveň vysokého prostorového i časového rozlišení.
Počítačové zpracování obrazů a prostorová rekonstrukce objektů
Konfokální obrazy optických řezů vznikají v číselné (digitální) formě a lze je proto dále upravovat všemi běžnými způsoby počítačového zpracování obrazů. Specialitou konfokální mikroskopie je možnost prostorové rekonstrukce mikroskopických objektů, opírající se o několik desítek až stovek optických řezů jedním objektem, postupně snímaných při plynule se měnící hloubce zaostření. Ze souboru optických řezů lze mimo jiné generovat stereoskopické páry – zvětšené obrazy celého trojrozměrného objektu viděné pravým a levým okem. Stereoskopické páry skýtají velmi působivé plastické obrazy preparátů. Ze souboru horizontálních řezů lze také rekonstruovat vertikální optické řezy vzorkem. Vertikální řezy se ovšem dají získat i přímým způsobem, vhodnou volbou rastrovacího algoritmu mikroskopu. Další, poměrně nová metoda konfokální mikroskopie spočívá v současném snímání fluorescenčních obrazů pomocí tří fotonásobičů se spektrálními filtry pro modrou, zelenou a červenou barvu. Rekombinací dílčích obrazů v základních barvách získáme optický řez v reálných barvách emitované fluorescence.Aplikace konfokální mikroskopie. Unikátní schopnosti konfokálního mikroskopu zobrazovat preparáty s trojrozměrným rozlišením se využívá při studiu povrchových vlastností materiálů. V reflexním modu zobrazování se zkoumá textura a složení povrchů i eroze materiálů.
Konfokálním mikroskopem se vyhodnocují výsledky mikrotestů tvrdosti kovů i plastických materiálů, měří se výška strukturních elementů na polovodičových čipech. Biologie a lékařský výzkum těží ze skutečnosti, že konfokální mikroskopie je ve své podstatě neinvazivním a nedestruktivním způsobem studia prostorové struktury buněk a tkání. Příkladem, kdy konfokální mikroskopie bezesporu převyšuje možnosti metod klasické mikroskopie, může být studium složité architektury neuronových sítí v mozkové tkáni (používá se klasické Golgiho metody kontrastování neuronů částečkami stříbra, které ideálně odrážejí světlo). Konfokálním mikroskopem lze pomocí speciálních fluorescenčních sond studovat intracelulární koncentrace fyziologicky významných iontů (např. K+, Ca2+), měřit membránový potenciál nebo vnitrobuněčné pH. Imunofluorescenčními metodami, které jsou založeny na přesné chemické specifitě fluorescenčně značených protilátek, se studuje rozložení receptorů v membránách, organizace cytoskeletu, mitotický aparát během dělení, či struktura endoplazmatického retikula. V mnoha případech je zlepšení kontrastu při konfokální mikroskopii tak dramatické, že se vyjeví buněčné struktury, které při použití klasického mikroskopu nejsou vůbec pozorovatelné.
Literatura
Pawley J. B., (edit.) Handbook of Confocal Microscopy, Plenum Press, New York 1990Petráň M. a Hadravský M., Způsob a zařízení pro omezení rozptylu světla v mikroskopu pro osvětlení shora. Gs. patent No 128936, udělen 15. 2. 1968 Egger M. D., Petráň M., Science 157 (1967) 305
Plášek J., Nové metody optické mikroskopie. Pokroky matematiky, fyziky a astronomie (1995), v tisku
Spojením Rayleighova kritéria s teorií difrakce na kruhovém otvoru se dospělo ke známému odhadu minimální vzdálenosti dvou rozlišitelných bodů:
Xmin = 0,61 . λ / n sin θ
kde λ je vlnová délka světla ve vakuu, n index lomu prostředí před objektivem a θ je polovina vrcholového úhlu kužele paprsků, které mohou vstoupit do objektivu (Obrázek). Veličina n sin θ je tzv. numerická apertura objektivu (NA). Numerická apertura nejkvalitnějších objektivů bývá ~ 1,3 1,4.